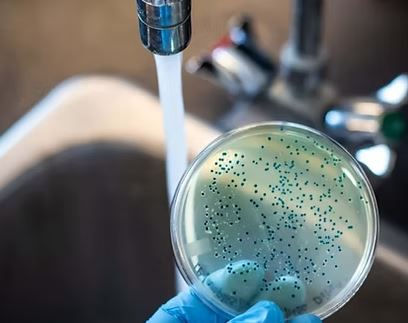

top of page
Service Request
1 hr
800 South African rand1 hr
1,650 South African rand15 min
1,400 South African rand1 hr
1,650 South African rand1 hr
1,650 South African rand15 min
2,900 South African rand1 hr
1,650 South African rand

bottom of page
.png)